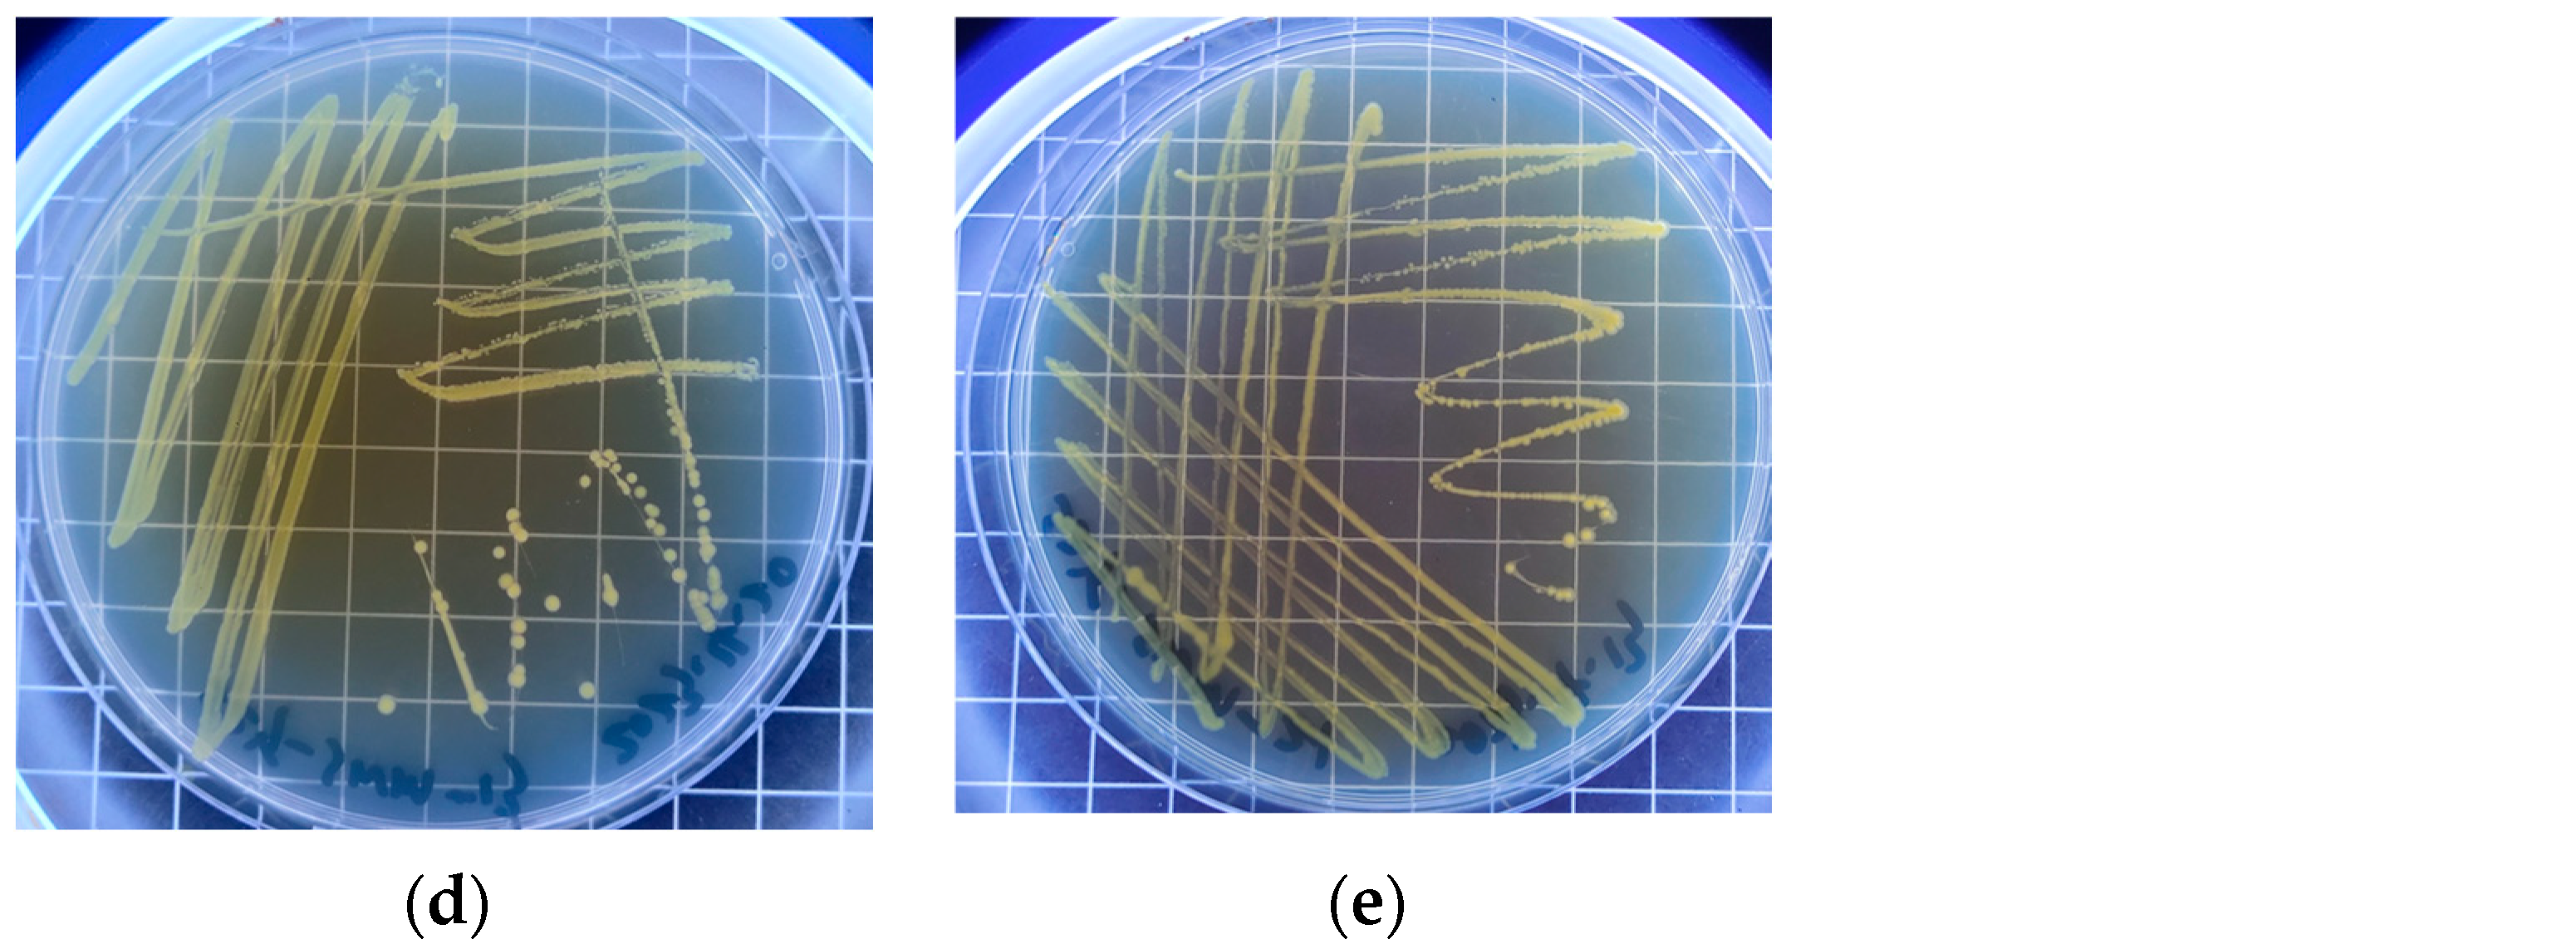
Sustainability 16 07357 g0a1b

Distribution of Carbon-Sequestering Microbes in Different Habitats and the Interaction with Habitat Factors in a Natural Karst Cave
Abstract
1. Introduction
2. Materials and Methods
2.1. Study Area and Sampling
2.2. Carbon-Free Inorganic Medium Composition
2.3. Physicochemical Analysis
2.4. Isolation, Purification, and Screening of Carbon-Sequestering Strains
2.5. DNA Extraction and Sequencing
2.5.1. Sequencing of Microbial Communities
2.5.2. Sequencing of cbbL-Related Carbon-Sequestering Microbes
2.6. Carbon-Sequestering Strains Identification
2.7. Bioinformatics and Statistical Analysis
3. Results
3.1. Physicochemical Characteristics of Different Habitats in Shiziyan Cave
3.2. Microbial Community and Their Diversity in Shiziyan Cave
3.3. Screening of the Predominant Carbon-Sequestering Strains in Shiziyan Cave
3.4. Community Structure of the Carbon-Sequestering Bacteria in Shiziyan Cave
3.5. Inferring Microbial Carbon Metabolic Function in Cave Samples by PICRUSt2
4. Discussion
4.1. Distribution of Culturable Carbon-Sequestering Bacteria in Shiziyan Cave
4.2. Structure of Carbon-Sequestering Microbes in Different Habitats
4.3. Effects of Habitat Factors on the Structure of Carbon-Sequestering Microbes in Shiziyan Cave
4.4. Functional Potential of Carbon Metabolism in Cave Microbes
5. Conclusions
Supplementary Materials
Author Contributions
Funding
Institutional Review Board Statement
Informed Consent Statement
Data Availability Statement
Conflicts of Interest
Appendix A

References
- Falkowski, P.; Scholes, R.J.; Boyle, E.; Canadell, J.; Canfield, D.; Elser, J.; Gruber, N.; Hibbard, K.; Hogberg, P.; Linder, S.; et al. The global carbon cycle: A test of our knowledge of earth as a system. Science 2000, 290, 291–296. [Google Scholar] [CrossRef] [PubMed]
- Wang, Z.; Yin, J.-J.; Pu, J.; Xiao, Q.; Zhang, T.; Li, J. Flux and influencing factors of CO2 outgassing in a karst spring-fed creek: Implications for carbonate weathering-related carbon sink assessment. J. Hydrol. 2021, 596, 125710. [Google Scholar] [CrossRef]
- Marques, E.; Dias, J.; Silva, G.; Pirovani, C.; Rezende, R. Organic matter enrichment affects archaea community in limestone cave sediments. J. Cave Karst Stud. 2017, 79, 95–99. [Google Scholar] [CrossRef]
- Buckerfield, S.J.; Waldron, S.; Quilliam, R.S.; Naylor, L.A.; Li, S.; Oliver, D.M. How can we improve understanding of faecal indicator dynamics in karst systems under changing climatic, population, and land use stressors?—Research opportunities in SW China. Sci. Total Environ. 2019, 646, 438–447. [Google Scholar] [CrossRef]
- Jiang, C.; Zeng, H. Unique habitat of Karst Tiankengs changes the taxonomy and potential metabolism of soil microbial communities. Microbiol. Spectr. 2023, 11, e0231622. [Google Scholar] [CrossRef]
- Ortiz, M.; Legatzki, A.; Neilson, J.W.; Fryslie, B.; Nelson, W.M.; A Wing, R.; A Soderlund, C.; Pryor, B.M.; Maier, R.M. Making a living while starving in the dark: Metagenomic insights into the energy dynamics of a carbonate cave. ISME J. 2014, 8, 478–491. [Google Scholar] [CrossRef]
- Martin-Pozas, T.; Cuezva, S.; Fernandez-Cortes, A.; Gonzalez-Pumariega, M.; Elez, J.; Duarte, E.; de la Rasilla, M.; Canaveras, J.C.; Saiz-Jimenez, C.; Sanchez-Moral, S. Adaptive response of prokaryotic communities to extreme pollution flooding in a Paleolithic rock art cave (Pindal Cave, northern Spain). Sci. Total Environ. 2024, 921, 171137. [Google Scholar] [CrossRef]
- Man, B.; Wang, H.; Xiang, X.; Wang, R.; Yun, Y.; Gong, L. Phylogenetic diversity of culturable fungi in the Heshang Cave, central China. Front. Microbiol. 2015, 6, 1158. [Google Scholar] [CrossRef]
- Bauermeister, J.; Ramette, A.; Dattagupta, S. Repeatedly evolved host-specific ectosymbioses between sulfur-oxidizing bacteria and amphipods living in a cave ecosystem. PLoS ONE 2012, 7, e50254. [Google Scholar] [CrossRef]
- De Mandal, S.; Chatterjee, R.; Kumar, N.S. Dominant bacterial phyla in caves and their predicted functional roles in C and N cycle. BMC Microbiol. 2017, 17, 90. [Google Scholar] [CrossRef]
- Li, Y.; Liu, X.; Zhang, L.; Xie, Y.; Cai, X.; Wang, S.; Lian, B. Effects of short-term application of chemical and organic fertilizers on bacterial diversity of cornfield soil in a karst area. J. Soil Sci. Plant Nutr. 2020, 20, 2048–2058. [Google Scholar] [CrossRef]
- Lu, L.; Zou, S.Z.; Zhao, Y. Response of water cycle to precipitation in Shizhiyan underground river system in Huixian wetland of Guilin. Chin. Hydrogeol. Eng. Geol. 2022, 49, 63–72. [Google Scholar]
- Hu, J.-J.; Wang, L.; Li, Y.-L.; Fu, X.-H.; Le, Y.-Q.; Xu, D.-S.; Lu, B.; Yu, J.-G. Breeding, optimization and community structure analysis of non-photosynthetic CO2 assimilation microbial flora. Huan Jing ke Xue = Huanjing Kexue 2009, 30, 2438–2444. [Google Scholar]
- Zhou, S.; Wei, B.Q.; Zhang, Q.; Jiang, X.J.; Lin, D.C.; Gan, Y.K.; Mo, Z.Z. Isolation, identification and validation of the facultative fixed carbon and nitrogen bacteria: A type of microorganisms that can fix CO2 and N2 at the same time. Acta Sci. Circumstantiae 2013, 33, 1043–1050. [Google Scholar]
- Fan, X.R.; Li, G.W.; Shen, P. Microbiology Experiment, 2nd ed.; Higher Education Press: Beijing, China, 1995; pp. 107–112. [Google Scholar]
- Bu, L.; Peng, Z.; Tian, J.; Zhang, X.; Chen, W.; An, D.; Wei, G.; Wang, H. Core autotrophic microbes drive functional stability of soil cbbL-containing autotrophic microbes during desertification. Appl. Soil Ecol. 2023, 190, 105027. [Google Scholar] [CrossRef]
- Cao, J.; Cheng, X.; Zeng, Z.; Yang, Z.; Liu, X.; Wang, H.; Ma, L.; Lu, X.; Su, C.; Huang, Q. Habitat specificity and co-occurrence network of bacterial communities in the Xincuntun Cave, Guilin, Guangxi. Chin. Sci. Bull. 2021, 66, 4003–4016. [Google Scholar] [CrossRef]
- Yang, Z.Q.; Cheng, X.Y.; Wang, H.M.; Zeng, Z.L.; Liu, X.Y.; Cao, J.; Su, C.T.; Huang, Q.B. Environmental driving mechanisms and community assembly process of bacterial communities in the Luohandu Cave, Guilin, Guangxi Province, China. Chin. Acta Microbiol. Sin. 2021, 61, 4118–4136. [Google Scholar]
- Xiang, S.; Li, Y.; Wang, W.; Zhang, B.; Shi, W.; Zhang, J.; Huang, F.; Liu, F.; Guan, X. Antibiotics adaptation costs alter carbon sequestration strategies of microorganisms in karst river. Environ. Pollut. 2021, 288, 117819. [Google Scholar] [CrossRef]
- Hügler, M.; Wirsen, C.O.; Fuchs, G.; Taylor, C.D.; Sievert, S.M. Evidence for autotrophic CO2 fixation via the reductive tricarboxylic acid cycle by members of the ε subdivision of Proteobacteria. J. Bacteriol. 2005, 187, 3020–3027. [Google Scholar] [CrossRef]
- Liu, S.; Li, X.; Fu, Y.; Li, P.; Qiao, J.; Li, H.; Wu, L.; Wang, B.; Lu, S. Exploring the effects of different fertilizer application durations on the functional microbial profiles of soil carbon and nitrogen cycling by using metagenomics in Paulownia plantations in a subtropical zone. Eur. J. For. Res. 2024, 143, 955–969. [Google Scholar] [CrossRef]
- Dong, Y.; Gao, J.; Wu, Q.; Ai, Y.; Huang, Y.; Wei, W.; Sun, S.; Weng, Q. Co-occurrence pattern and function prediction of bacterial community in Karst cave. BMC Microbiol. 2020, 20, 137. [Google Scholar] [CrossRef]
- Ma, L.; Huang, X.; Wang, H.; Yun, Y.; Cheng, X.; Liu, D.; Lu, X.; Qiu, X. Microbial interactions drive distinct taxonomic and potential metabolic responses to habitats in karst cave ecosystem. Microbiol. Spectr. 2021, 9, e0115221. [Google Scholar] [CrossRef] [PubMed]
- Xiao, D.; He, X.; Zhang, W.; Hu, P.; Sun, M.; Wang, K. Comparison of bacterial and fungal diversity and network connectivity in karst and non-karst forests in southwest China. Sci. Total Environ. 2022, 822, 153179. [Google Scholar] [CrossRef] [PubMed]
- Yan, Z.; Shen, T.; Li, W.; Cheng, W.; Wang, X.; Zhu, M.; Yu, Q.; Xiao, Y.; Yu, L. Contribution of microalgae to carbon sequestration in a natural karst wetland aquatic ecosystem: An in-situ mesocosm study. Sci. Total Environ. 2021, 768, 144387. [Google Scholar] [CrossRef] [PubMed]
- Chen, J.; Li, Q.; He, Q.; Schröder, H.C.; Lu, Z.; Yuan, D. Influence of CO2/HCO3− on microbial communities in two karst caves with high CO2. J. Earth Sci. 2023, 34, 145–155. [Google Scholar] [CrossRef]
- Sperlea, T.; Kreuder, N.; Beisser, D.; Hattab, G.; Boenigk, J.; Heider, D. Quantification of the covariation of lake microbiomes and environmental variables using a machine learning-based framework. Mol. Ecol. 2021, 30, 2131–2144. [Google Scholar] [CrossRef]
- Hermans, S.M.; Buckley, H.L.; Case, B.S.; Curran-Cournane, F.; Taylor, M.; Lear, G. Bacteria as emerging indicators of soil condition. Appl. Environ. Microbiol. 2017, 83, e02826-16. [Google Scholar] [CrossRef]
- Lewin, G.R.; Carlos, C.; Chevrette, M.G.; Horn, H.A.; McDonald, B.R.; Stankey, R.J.; Fox, B.G.; Currie, C.R. Evolution and ecology of Actinomycetota and their bioenergy applications. Annu. Rev. Microbiol. 2016, 70, 235–254. [Google Scholar] [CrossRef]
- Shi, J.; Jiang, G.; Sun, Z.; Guo, F.; Wang, Q.; Liu, F. Dissolved organic matter tracers reveal contrasting characteristics in the concentrated flow zone and matrix-with-fractures zone of a sulfate-contaminated karst aquifer in South China. Appl. Geochem. 2022, 146, 1054. [Google Scholar] [CrossRef]
- Jiang, X.T.; Zhang, H.; Sheng, H.F.; Wang, Y.; He, Y.; Zou, F.; Zhou, H.W. Two-Stage Clustering (TSC): A pipeline for selecting operational taxonomic units for the high-throughput sequencing of PCR amplicons. PLoS ONE 2017, 7, 30230. [Google Scholar] [CrossRef]
- Guo, L.; Wang, G.; Sheng, Y.; Shi, Z.; Sun, X. Groundwater microbial communities and their connection to hydrochemical environment in Golmud, Northwest China. Sci. Total Environ. 2019, 695, 133848. [Google Scholar] [CrossRef] [PubMed]
- Fan, Z.; Lu, S.; Liu, S.; Guo, H.; Wang, T.; Zhou, J.; Peng, X. Changes in plant rhizosphere microbial communities under different vegetation restoration patterns in karst and non-karst ecosystems. Sci. Rep. 2019, 9, 8761. [Google Scholar] [CrossRef] [PubMed]
- Parker, C.W.; Wolf, J.A.; Auler, A.S.; Barton, H.A.; Senko, J.M. Microbial reducibility of Fe(III) phases associated with the genesis of iron ore caves in the iron quadrangle, Minas Gerais, Brazil. Minerals 2013, 3, 395–411. [Google Scholar] [CrossRef]
- Jones, D.S.; Macalady, J.L. The snotty and the stringy: Energy for subsurface life in caves. In Their World: A Diversity of Microbial Environments; Springer: Berlin/Heidelberg, Germany, 2016; Volume 1, pp. 203–224. [Google Scholar]
- Lyu, X.; Shen, C.; Xie, J.; Fu, Y.; Jiang, D.; Hu, Z.; Tang, L.; Tang, L.; Ding, F.; Li, K.; et al. A “footprint” of plant carbon fixation cycle functions during the development of a heterotrophic fungus. Sci. Rep. 2015, 5, 12952. [Google Scholar] [CrossRef] [PubMed]
- Berg, I.A.; Kockelkorn, D.; Ramos-Vera, W.H.; Say, R.F.; Zarzycki, J.; Hügler, M.; Alber, B.E.; Fuchs, G. Autotrophic carbon fixation in archaea. Nat. Rev. Microbiol. 2010, 8, 447–460. [Google Scholar] [CrossRef]
- Huber, H.; Gallenberger, M.; Jahn, U.; Eylert, E.; Berg, I.A.; Kockelkorn, D.; Eisenreich, W.; Fuchs, G. A dicarboxylate/4-hydroxybutyrate autotrophic carbon assimilation cycle in the hyperthermophilic Archaeum Ignicoccus hospitalis. Proc. Natl. Acad. Sci. USA 2008, 105, 7851–7856. [Google Scholar] [CrossRef]











| Habitat | Type | Name | Number | Location Point |
|---|---|---|---|---|
| FHYB | weathered rock wall samples | QB-1, 2 | 2 | twilight zone |
| RB-1, 2 | 2 | dark zone | ||
| CJW | sediment samples | QC-1, 2, 3 | 3 | twilight zone |
| RC-1, 2 | 2 | dark zone | ||
| DXDS | drip water samples | QD-1, 2, 3 | 3 | twilight zone |
| RD-1, 2, 3 | 3 | dark zone | ||
| DXHS | underground river water samples | QS-1, 2 | 2 | twilight zone |
| RS-1 | 1 | dark zone | ||
| AC | air samples | AC-1, 2 | 2 | twilight zone |
| AC-3, 4 | 2 | dark zone |
| Sample Types | Num. | pH | TOC (%) | TIC (%) | K+ (mg/L) | Na+ (mg/L) | Ca2+ (mg/L) | Mg2+ (mg/L) | Cl− (mg/L) | (mg/L) | (mg/L) |
|---|---|---|---|---|---|---|---|---|---|---|---|
| CJW | CJW1 | 7.15 | 5.50 | 2.64 | 0.59 | 0.56 | 149.92 | 3.39 | 1.93 | 17.92 | 5.80 |
| CJW2 | 7.63 | 4.29 | 2.43 | 1.78 | 1.98 | 96.38 | 4.65 | 2.61 | 20.23 | 12.74 | |
| CJW3 | 7.67 | 6.60 | 2.22 | 0.73 | 0.31 | 99.02 | 1.86 | 2.13 | 15.09 | 4.18 | |
| DXHS | DXHS1 | 7.62 | 2.25 | 2.38 | Na 1 | Na 1 | 53.10 | 1.06 | 1.85 | 6.37 | 4.07 |
| DXHS2 | 7.60 | 2.53 | 0.21 | 0.05 | 0.02 | 39.31 | 1.64 | 2.54 | 11.33 | 10.95 | |
| DXHS3 | 7.55 | 3.02 | 2.23 | 0.16 | 0.13 | 5.82 | 0.43 | 4.70 | 10.83 | 14.00 |
| Habitats | Chao1 | ACE | Shannon | Simpson |
|---|---|---|---|---|
| FHYB | 514.82 ± 28.42 bc | 514.43 ± 27.86 bc | 4.41 ± 0.33 bc | 0.94 ± 0.03 ab |
| DXHS | 644.72 ± 168.81 abc | 646.30 ± 170.28 abc | 5.28 ± 0.07 ab | 0.99 ± 0.00 a |
| DXDS | 997.20 ± 165.14 ab | 993.10 ± 164.10 ab | 5.38 ± 0.33 a | 0.97 ± 0.02 a |
| CJW | 1174.96 ± 240.50 a | 1180.60 ± 242.37 a | 6.00 ± 0.16 a | 0.99 ± 0.00 a |
| AC | 138.58 ± 47.79 c | 135.66 ± 42.55 c | 1.26 ± 0.19 c | 0.50 ± 0.03 b |
| Name | Habitat | Scientific Name | Gram Stain | Colony Description | SEM Observation |
|---|---|---|---|---|---|
| DXHS-31 | FHYB | Microbacterium zeae | positive | yellow, and the diameter of single colony is about 1 mm | short rod with a smooth surface |
| DXDS-21 | DXDS | Paracoccus aerius | negative | yellow, and the diameter of single colony is about 4.5 mm | ball-shaped with an uneven surface |
| DXHS-11 | DXHS | Arthrobacter bussei | positive | orange, and the diameter of single colony is about 3 mm | short rod with an uneven surface |
| CJW-11 | CJW | Agromyces arachidis | positive | yellow, and the diameter of single colony is about 2.5 mm | oval-shaped with an uneven and crumpled surface |
| CJW-13 | CJW | Microbacterium flavescens | positive | light yellow, and the diameter of single colony is about 1.5 mm | short rod with a smooth surface |
| CJW-21 |
Disclaimer/Publisher’s Note: The statements, opinions and data contained in all publications are solely those of the individual author(s) and contributor(s) and not of MDPI and/or the editor(s). MDPI and/or the editor(s) disclaim responsibility for any injury to people or property resulting from any ideas, methods, instructions or products referred to in the content. |
© 2024 by the authors. Licensee MDPI, Basel, Switzerland. This article is an open access article distributed under the terms and conditions of the Creative Commons Attribution (CC BY) license (https://creativecommons.org/licenses/by/4.0/).
Share and Cite
Xu, W.; Liao, L.; Liao, D.; Li, F.; Qin, A.; Mo, S.; Zhou, X.; Fan, Y. Distribution of Carbon-Sequestering Microbes in Different Habitats and the Interaction with Habitat Factors in a Natural Karst Cave. Sustainability 2024, 16, 7357. https://doi.org/10.3390/su16177357
Xu W, Liao L, Liao D, Li F, Qin A, Mo S, Zhou X, Fan Y. Distribution of Carbon-Sequestering Microbes in Different Habitats and the Interaction with Habitat Factors in a Natural Karst Cave. Sustainability. 2024; 16(17):7357. https://doi.org/10.3390/su16177357
Chicago/Turabian StyleXu, Wei, Lei Liao, Dongliang Liao, Fuli Li, Aimiao Qin, Shengpeng Mo, Xiaobin Zhou, and Yinming Fan. 2024. "Distribution of Carbon-Sequestering Microbes in Different Habitats and the Interaction with Habitat Factors in a Natural Karst Cave" Sustainability 16, no. 17: 7357. https://doi.org/10.3390/su16177357
APA StyleXu, W., Liao, L., Liao, D., Li, F., Qin, A., Mo, S., Zhou, X., & Fan, Y. (2024). Distribution of Carbon-Sequestering Microbes in Different Habitats and the Interaction with Habitat Factors in a Natural Karst Cave. Sustainability, 16(17), 7357. https://doi.org/10.3390/su16177357
